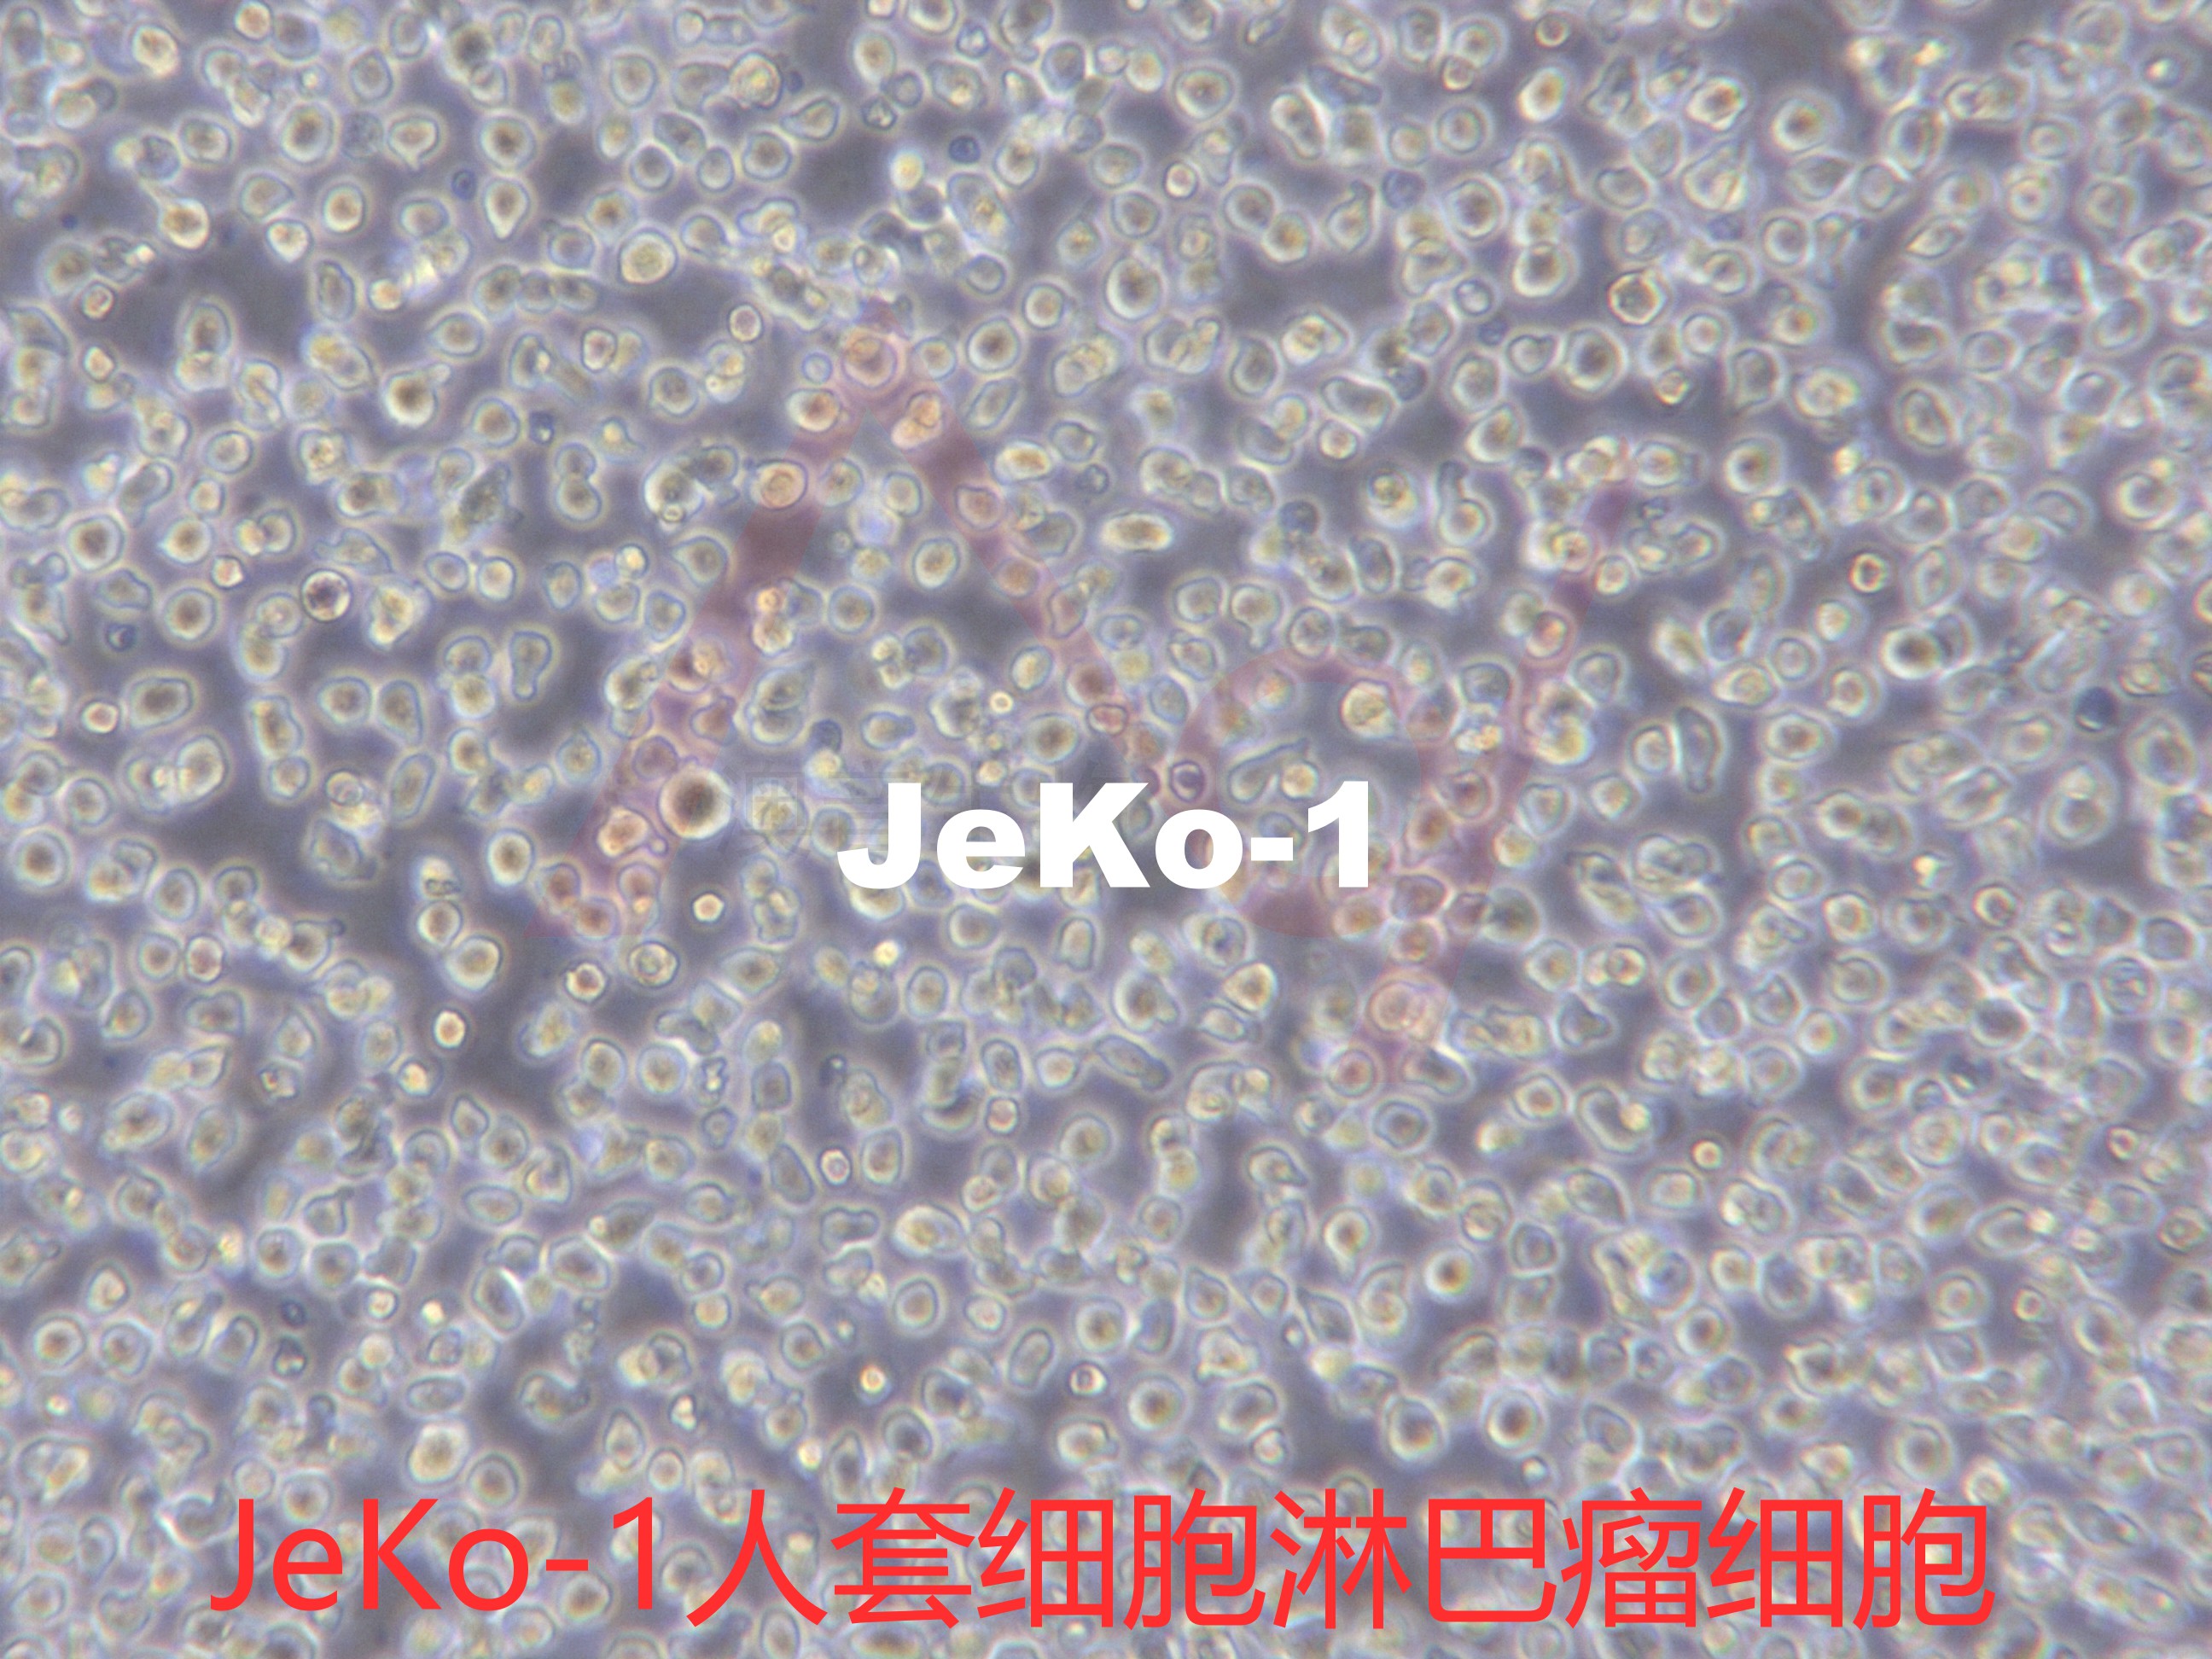
产品封面图

相关产品推荐更多 >
![MCF-7-LUC-RFP-Puro[mcf7-luc;mcf7-rfp;MCF7/LUC;MCF7/RFP]双标记的人乳腺癌细胞](https://img1.dxycdn.com/2022/1019/561/8014327431113608753-14.jpg!wh200)
MCF-7-LUC-RFP-Puro[mcf7-luc;mcf7-rfp;MCF7/LUC;MCF7/RFP]双标记的人乳腺癌细胞
¥3500
L-929【 L-929; L 929; L929; L929(NCTC);NCTC 929; NCTC-929; NCTC929; L cell; L cells; L-cell; L-cells; L cell line; L; Strain L-929; Clone 929; Earles's cells; Earle's L cells】小鼠成纤维细胞
¥1000![GES-1[GES-1;GES1]胃黏膜上皮细胞](https://img1.dxycdn.com/2020/1106/370/6811452527972995443-14.jpg!wh200)
GES-1[GES-1;GES1]胃黏膜上皮细胞
¥1000![MDA-MB-231-LUC-GFP-Puro[MDA-MB-231-LUC;MDA-MB-231-GFP]双标记的人乳腺癌细胞](https://img1.dxycdn.com/2021/1230/020/3262885249537563253-14.jpg!wh200)
MDA-MB-231-LUC-GFP-Puro[MDA-MB-231-LUC;MDA-MB-231-GFP]双标记的人乳腺癌细胞
¥3500
L6【L-6; L-6 myoblast】大鼠骨骼肌成肌细胞
¥1000
万千商家帮你免费找货
0 人在求购买到急需产品
- 详细信息
- 技术资料
- 英文名:
JeKo-1
- 库存:
1×10^6
- 供应商:
澳音生物
- 肿瘤类型:
--
- 细胞类型:
淋巴母细胞
- 品系:
--
- 组织来源:
套细胞淋巴瘤
- 相关疾病:
淋巴瘤
- 物种来源:
人
- 免疫类型:
--
- 细胞形态:
淋巴母细胞样
- 是否是肿瘤细胞:
是
- 器官来源:
外周血
- 运输方式:
复苏发货或干冰冷冻发货
- 年限:
--
- 生长状态:
贴壁
- 规格:
T25
JeKo-1人套细胞淋巴瘤细胞(通过STR鉴定)
以上产品图片均为本公司细胞出入库时拍摄
培养条件:
培养基:RPMI-1640,80%;优质胎牛血清,20%。
气相:空气,95%;二氧化碳,5%。
温度:37摄氏度。
STR信息:
描述:一位套细胞淋巴瘤患者的巨细胞变种显示白血病转变,从其外周血单核细胞出发建立了MCL细胞株JeKo-1。 JeKo-1细胞EB病毒阴性,并表达一种B细胞表型的IgM。 细胞过表达cyclin D1, Bcl-2, c-Myc 及 Rb 蛋白。 Bcl-1/J(H)基因重排得到了PCR证实。 JeKo-1细胞在SCID小鼠中高成瘤。
ATCC参考图片:
收到货后处理方式:
1.细胞冻存管: 收到货物后,请检查箱子里面是否还有干冰。
● 若干冰已剩余不多,不能掩埋冻存管,请及时拍照,并第一时间联系销售。
● 若干冰充裕,可以安排复苏细胞,复苏方法参考【说明书】;不安排复苏,请将细胞冻存管转移到液氮进行保存。短期(一周内)的存放可以放在-80冰箱,建议最好保存在液氮中。
2.培养瓶的活细胞: 收到请检查培养瓶是否完好,是否有漏液,培养基是否浑浊
●若出现以上问题请于当天和我们销售取得联系,我们会第一时间为您处理。
● 若以上问题都没有出现:拆掉培养瓶的外包装,在显微镜下对细胞进行多个视野,不同倍镜拍照。然后用酒精对瓶身进行彻底消毒,放在37度二氧化碳培养箱中进行复温。1-2小时后,拿出在显微镜下观察,并进行多个视野不同倍镜拍照。若细胞达到了可以传代的密度,请按照【说明书】的传代方法进行操作。若细胞密度不能进行传代,请回收培养瓶中的培养基,留适量培养基在瓶中,并将培养瓶放在培养箱继续培养即可(个别细胞除外,详见说明书)
仅供研究之用
联系我们:
以上产品图片均为本公司细胞出入库时拍摄
培养条件:
培养基:RPMI-1640,80%;优质胎牛血清,20%。
气相:空气,95%;二氧化碳,5%。
温度:37摄氏度。
STR信息:
描述:一位套细胞淋巴瘤患者的巨细胞变种显示白血病转变,从其外周血单核细胞出发建立了MCL细胞株JeKo-1。 JeKo-1细胞EB病毒阴性,并表达一种B细胞表型的IgM。 细胞过表达cyclin D1, Bcl-2, c-Myc 及 Rb 蛋白。 Bcl-1/J(H)基因重排得到了PCR证实。 JeKo-1细胞在SCID小鼠中高成瘤。
ATCC参考图片:
收到货后处理方式:
1.细胞冻存管: 收到货物后,请检查箱子里面是否还有干冰。
● 若干冰已剩余不多,不能掩埋冻存管,请及时拍照,并第一时间联系销售。
● 若干冰充裕,可以安排复苏细胞,复苏方法参考【说明书】;不安排复苏,请将细胞冻存管转移到液氮进行保存。短期(一周内)的存放可以放在-80冰箱,建议最好保存在液氮中。
2.培养瓶的活细胞: 收到请检查培养瓶是否完好,是否有漏液,培养基是否浑浊
●若出现以上问题请于当天和我们销售取得联系,我们会第一时间为您处理。
● 若以上问题都没有出现:拆掉培养瓶的外包装,在显微镜下对细胞进行多个视野,不同倍镜拍照。然后用酒精对瓶身进行彻底消毒,放在37度二氧化碳培养箱中进行复温。1-2小时后,拿出在显微镜下观察,并进行多个视野不同倍镜拍照。若细胞达到了可以传代的密度,请按照【说明书】的传代方法进行操作。若细胞密度不能进行传代,请回收培养瓶中的培养基,留适量培养基在瓶中,并将培养瓶放在培养箱继续培养即可(个别细胞除外,详见说明书)
仅供研究之用
联系我们:
风险提示:丁香通仅作为第三方平台,为商家信息发布提供平台空间。用户咨询产品时请注意保护个人信息及财产安全,合理判断,谨慎选购商品,商家和用户对交易行为负责。对于医疗器械类产品,请先查证核实企业经营资质和医疗器械产品注册证情况。
技术资料暂无技术资料 索取技术资料
JeKo-1【Jeko-1; JEKO-1; JeKo 1; Jeko1; JEKO1; JEKO】人套细胞淋巴瘤细胞
¥1000